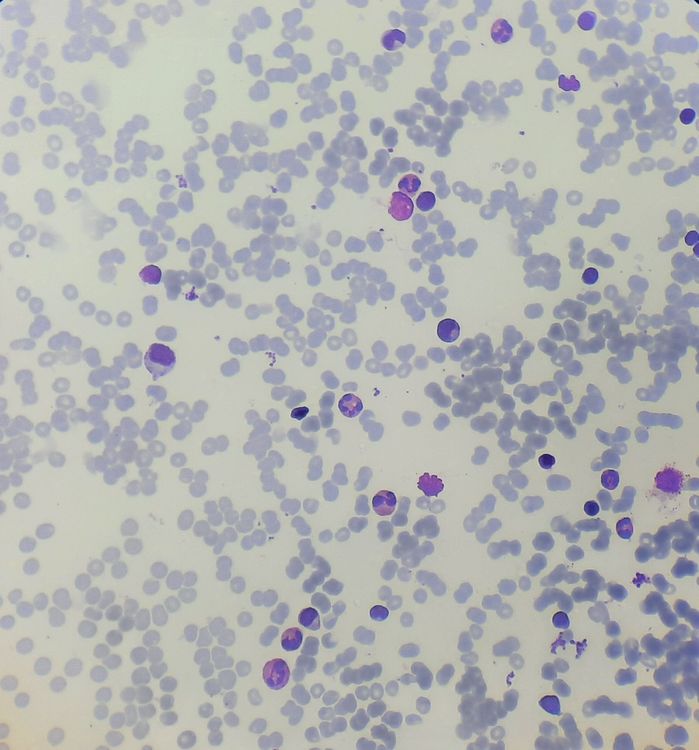
Pure Red Cell Aplasia howitreat.in

L'aplasia eritroide pura non è una malattia unica dal punto di vista eziologico, ma dal punto di vista clinico, dato che presenta un quadro sintomatologico ed ematologico unico. La malattia può essere genetica o acquisita e nel secondo caso può essere acuta o cronica
Epidemiologia ed eziopatologia delle tre forme
Eritroblastopenia acuta acquisita
È stata rilevata una correlazione con l'infezione da Parvovirus B19, mancano le dirette evidenze che collegherebbero le due malattie, pertanto l'eziologia di questa forma è sconosciuta, tuttavia si esclude un'origine genetica.
Eritroblastopenia acquisita cronica
Più frequente nei maschi adulti e anziani rivela una associazione significativa ma bassa (del 10-15%) con i timomi quindi se ne è ipotizzata, e verificata, l'origine autoimmune. Sono state trovate nel midollo molecole inibitorie di origine linfocitaria, ovvero immunoglobuline oppure altre molecole secrete da linfociti T.
Eritroblastopenia congenita (o anemia di Diamond-Blackfan)
Chiamata anche anemia di Diamond-Blackfan, si sono dimostrate diverse mutazioni sul locus 19q13.2, ma il prodotto genico è ignoto, impedendo lo sviluppo di una teoria che possa relazionare la causa e l'effetto.
Clinica
Semeiotica e laboratorio
I sintomi per la forma acuta sono i sintomi tipici dell'anemia, questi tuttavia non si presentano nelle forme croniche in quanto l'organismo si è adattato. In tutti i casi si rileva un quadro di ipoplasia eritroide con cellule normocitiche e normocromiche e ridotta reticolocitosi, le altre filiere sono intatte sia nello striscio che nell'agoaspirato midollare dove si nota la riduzione delle cellule della linea eritroide
Trattamento
La forma acuta di solito si risolve spontaneamente mentre nelle forma croniche si inizia una terapia di supporto con emotrasfusione con tutti i problemi legati alla pratica. Nel caso di associazione con timoma, la rimozione della neoplasia in un 50% dei casi risolve anche il problema ematologico associando una terapia immunosoppressiva con ciclosporina o ciclofosfamide.
Bibliografia
- G. Castoldi V. Liso malattie del sangue e degli organi ematopoietici. (IV ed.) McGraw-Hill
Voci correlate
- Aplasia